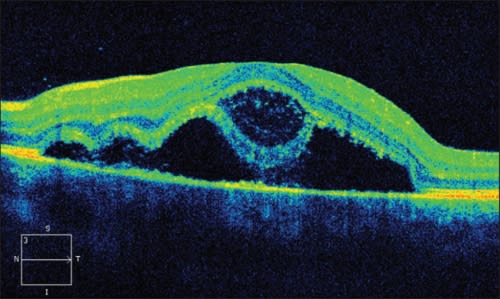

CASE STUDY
Rapid Resolution of Exudative Neurosensory RD in UAIM
A young man presents with sudden loss of central vision, resulting in an unusual diagnosis.
MATTHEW J. WELCH, MD · STEPHEN A. M. DE SOUZA, MD, FRCSC · ALAN J. GORDON, MD · MICHAEL S. TSIPURSKY, MD
|
Matthew J. Welch, MD, practices with Suburban Retina, Ltd., in Lombard, IL. Stephen A. M. De Souza, MD, FRCSC, and Alan J. Gordon, MD, practice with Associated Retina Consultants, Ltd., in Phoenix, AZ. Michael S. Tsipursky, MD, practices with Carle Physician Group in Urbana-Champaign, IL. None of the authors reports financial interests in any of the products mentioned in this article. Dr. Welch’s e-mail is mwelch11@gmail.com. |
Unilateral acute idiopathic maculopathy (UAIM), as first described by Yannuzzi et al in 1991, has been characterized as a central exudative maculopathy occurring mostly in young patients following a flu-like illness, with relatively prompt improvement in vision without therapeutic intervention and a residual bull’s-eye macular appearance.1
Since this initial characterization, UAIM has been described in association with Coxsackie virus and pseudo-hypopyon and masquerading as Best’s disease.2-4 The clinical spectrum of UAIM has also been expanded by Freund et al to include papillitis, bilateral pathology, and eccentric macular lesions.5
Further studies of UAIM have provided more detailed insight into findings on electro-oculography, electroretinography, autofluorescence, fluorescein angiography, indocyanine green angiography, and OCT that may be associated with this disease process.6-9
Here, we present a case that demonstrates further the rapid resolution of the central exudative neurosensory detachment that may develop in association with UAIM.
CASE PRESENTATION
A 20-year-old man presented with a five-day history of painless central vision loss in the left eye. Best-corrected visual acuity measured 20/20 in the right eye and 20/400 eccentrically in the left eye. Motility, confrontational visual fields, and IOP were all within normal limits. Amsler grid testing showed no abnormality in the right eye and a central scotoma in the left.
Imaging Series
Pupillary examination showed no afferent pupillary defect. Slit-lamp examination of the anterior segment of both eyes was unremarkable and showed the anterior vitreous to be clear and without cellular reaction.
Ophthalmoscopic examination of the right eye was unremarkable, but in the left eye revealed a 2-disc diameter area of well-circumscribed subretinal fluid centered on the fovea, with an adjacent pinpoint intraretinal hemorrhage superior to the foveal center. The optic disc and retinal vasculature were within normal limits.
Optical coherence tomography (Cirrus HD-OCT, Carl Zeiss Meditec, Dublin, CA) demonstrated prominent subretinal fluid and intraretinal cystoid spaces within the left macula and a central foveal thickness of 440 µm (Figure 1).
Early phases of the fluorescein angiogram showed evidence of irregular hyperfluorescence around the foveal center. Late-phase images showed evidence of irregular hyperfluorescence within the area of pooling, which corresponded to the region of macular serous detachment (Figure 2). OCT images and FA in the right eye were normal.
Second Visit
The patient returned nine days after the initial presentation and without interval treatment, and he reported having noticed some improvement in his left eye vision. Best-corrected visual acuity measured 20/20 in the right eye and 20/80 eccentrically in the left.
Figure 1. OCT (Cirrus HD-OCT, Carl Zeiss Meditec, Dublin, CA) shows prominent subretinal fluid and intraretinal cystoid spaces within the left macula. Central foveal thickness was 440 µm; visual acuity was 20/400 eccentrically.

Figure 2. Late-phase fluorescein angiogram image of the left eye shows irregular hyperfluorescence within a region of serous macular detachment.

Figure 3. Color fundus photograph shows central subfoveal pigmentary mottling without subretinal fluid 14 days after initial symptoms.

Figure 4. No evidence of subretinal fluid or intraretinal cystoid spaces appear in the left eye nine days after initial presentation. Central foveal thickness measured 200 µm, and visual acuity was 20/80 eccentrically.
Amsler grid testing showed improvement in the central scotoma noted on presentation. Slit-lamp examination remained unremarkable in both eyes. Ophthalmoscopic examination of the left eye showed central subfoveal pigmentary mottling without subretinal fluid (Figure 3). OCT testing showed no evidence of subretinal fluid or intraretinal cystoid spaces in the left eye (Figure 4).
Central foveal thickness now measured 200 µm. Despite the improvement in VA and subretinal fluid, OCT provided evidence of photoreceptor inner segment-outer segment disjunction over the entire area of the previous serous macular detachment. Fluorescein angiography showed evidence of central pigment mottling without hyperfluorescent areas or late pooling, as seen previously One week later, the patient’s vision improved to 20/40 in the left eye.
Further historical questioning revealed the patient had suffered from an oral infection related to recent wisdom tooth extraction, treated with oral antibiotics, followed by a nonspecific pharyngeal infection in the days preceding his initial vision changes in the left eye. The patient was otherwise well, without chronic medication use, steroid exposure, or undue stress.
DISCUSSION
Initial Patient Series
Yannuzzi et al, in their initial paper describing UAIM, reported on nine young patients 15-45 years old who had experienced an interval flu-like illness prior to the development of a central scotoma, which corresponded to a central exudative neurosensory detachment.
In this initial series of patients, spontaneous resolution of the exudative detachment occurred in three to six weeks.1 The significance of the case presented here is the 14-day course from onset of symptoms to complete spontaneous resolution of a substantial central exudative neurosensory detachment.
Yannuzzi et al in 1991 also characterized the FA findings in UAIM, describing them as irregular patterns of hyperfluorescence in early phases with irregular hyperfluorescence within a region of pooling in late phases. They attributed these late angiographic findings to the turbid nature of fluid within the subretinal space.
A Bulls-eye Appearance
Clinically, some patients displayed a bulls-eye appearance of pigmentary changes following resolution of serous macular detachment, with a central area of retinal pigment epithelium hyperpigmentation and an encircling area of hypopigmentation.1
We interpreted the late-phase angiogram images of our patient as having the irregular hyperfluorescent pattern Yannuzzi et al described, and eventually the characteristic bulls-eye appearance following serous detachment resolution, compared to the findings expected in central serous retinopathy. With this degree of historical and clinical consistency, we elected to defer serologic evaluation
Differential Diagnosis
As has been previously discussed by several authors, the differential diagnosis in such a case as ours would include central serous chorioretinopathy, Harada’s disease, idiopathic choroidal neovascularization, acute posterior multifocal placoid pigment epitheliopathy (APMPPE), and posterior scleritis.
In CSC, FA most often demonstrates a focal area of leakage and expansion into a large serous detachment or, less commonly, in what is considered the classical “smokestack” appearance of fluorescein dye leakage in late frames.
Harada’s disease can most certainly present with neuro-sensory detachment, but these detachments are most often small and multiple throughout the posterior pole, coupled with a cellular reaction in the vitreous cavity seen clinically.
In cases of idiopathic CNV, FA usually shows evidence of late dye leakage in association with subretinal fluid, which may develop into a form of neurosensory detachment.
While APMPPE is often the most commonly thought of retinal disease in association with a flu-like prodrome, it invariably does not include exudative neurosensory detachment in its clinical findings.
Posterior scleritis is most often associated with fluid accumulation in Tenon’s space, posteriorly forming the classic “T” sign, but it can also appear to have choroidal thickening on OCT imaging. This was not present in the current case.
CONCLUSION
UAIM can present with marked serous macular detachment and often may be clinically associated with recent viral (Coxsackie) illness. Although this case had no serologic testing, the rapid reduction of the serous macular detachment, coupled with the angiographic and OCT findings, makes UAIM the most likely clinical diagnosis. RP
REFERENCES
1. Yannuzzi LA, Jampol S, Rabb MF, Sorenson JA, Beyrer C, Wilcox LM Jr. Unilateral acute idiopathic maculopathy. Arch Ophthalmol. 1991;109:1411-1416.
2. Beck AP, Jampol LM, Glaser DA, Pollack JS. Is coxsackie virus the cause of unilateral acute idiopathic maculopathy? Arch Ophthalmol. 2004;122:121- 123.
3. Fish RH, Territo C, Anand R. Pseudohypopyon in unilateral acute idiopathic maculopathy. Retina. 1993;13:26-28.
4. Mathew MR, Webb LA, Bennett HG, Hammer HM. Unilateral acute idiopathic maculopathy (UAIM) masquerading as Best’s disease. Eye. 2002;16:496-497.
5. Freund KB, Yannuzzi LA, Barile GR, Spaide RF, Milewski SA, Guyer DR. The expanding clinical spectrum of unilateral acute idiopathic maculopathy. Arch Ophthalmol. 1996;114:555-559.
6. Lam BL, Lopez PF, Dubovy SR, Liu M. Transient electro-oculogram impairment in unilateral acute idiopathic maculopathy. Doc Ophthalmol. 2009;119:157- 161.
7. Day AC, Rotsos T, Holder GE, Tufail A, Robson AG. Electrodiagnostic and two-wavelength fundus autofluorescence imaging investigations in acute idiopathic maculopathy. Doc Ophthalmol. 2010;121:155-160.
8. Akduman L, Feiner MS, Pollack JS, Kaplan HJ. Progressive changes in the fluorescein and indocyanine green angiogram in acute idiopathic maculopathy. Ocul Immunol Inflamm. 1999;7:97-102.
9. Aggio FB, Farah ME, Meirelles RL, de Souza EC. STRATUSOCT and multifocal ERG in unilateral acute idiopathic maculopathy. Graefes Arch Clin Exp Ophthalmol. 2006;244:510-516.








